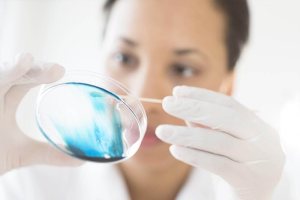

- Головна
- /
- Статті
- /
- Гастроентерологія
- /
- Лямблиоз: симптомы, диагностика и лечение
Лямблиоз: симптомы, диагностика и лечение
Лямблиоз – достаточно распространенное инфекционное заболевание, особенно в педиатрической практике (у детей он встречается в три раза чаще, чем у взрослых). Лямблиоз вызывают микроорганизмы группы простейших – лямблии (Giardia intestinalis, которая ранее была известна как Lamblia intestinalis или Giardia duodenalis).
Giardia intestinalis живут в двенадцатиперстной кишке и тонком кишечнике и провоцируют нарушение работы желудочно-кишечного тракта.
Заражение лямблиозом
Основным источником заражения является человек (больной или носитель). Механизм инфицирования – фекально-оральный – осуществляется несколькими путями:
- контактно-бытовое заражение у детей возникает в основном из-за игрушки, посуду и другие элементы быта, особенно во время игры ребенка в песочнице;
- водное заражение происходит при попадании в бассейне в ЖКТ (во время купания в открытом водоеме дети часто случайно заглатывают воду)
- пищевое заражение наступает при употреблении недостаточно обработанных сырых ягод, фруктов и овощей.
Дети часто инфицируются из-за несоблюдения элементарных правил гигиены. Такие «вредные» привычки, как сосание пальцев, игрушек и других предметов – самые «популярные» причины лямблиоза у детей. Пребывание ребенка в детском коллективе существенно повышает риск заражения этим микроорганизмом.
Развитие инфекции (инкубационный период) и симптомы лямблиоза
Инкубационный период после попадания лямблии в тонкий кишечник составляет от 5 дней до 4 недель. Продолжительность бессимптомного носительства зависит от состояния иммунной системы ребенка: проявления инфекции заметны быстрее при сниженном иммунитете.
Это заболевание проявляется в основном симптомокомплексами (синдромами):
| Гастроинтестинальный синдром | Интоксикационный синдром | Эксикоз |
|---|---|---|
|
|
|
После попадания цисты в двенадцатиперстную кишку она начинает быстро расти и размножаться. В процессе передвижения лямблии желудочно-кишечным трактом слизистая оболочка кишечника раздражается, наступают воспалительные изменения (дуоденит, энтерит). Чрезмерное раздражение слизистой оболочки вызывает дисфункцию желчевыводящих путей и желчного пузыря. Хотя попадание цисты лямблии в ЖКТ не всегда вызывает нарушение работы кишечника. В толстом кишечнике лямблия теряет свои «инвазивные» свойства и превращается в цисты.
В редких случаях возникают внекишечные проявления заболевания: боль в области сердца, учащенное сердцебиение, одышка.
Лямблиоз может быть острым и хроническим. Хроническое носительство паразита, который может активизироваться в случае нарушении иммунитета, стресса или воздействия других факторов.
Диагностика лямблиоза
Многообразные симптомы этого заболевания существенно затрудняют диагностику. Для постановки точного диагноза врачу следует придерживаться четкой последовательности обследования ребенка и правил проведения анализов. Проводятся следующие мероприятия:
Сбор жалоб и анамнеза. Наличие гастроинтестинального синдрома в сочетании с аллергическим компонентом (сыпь, зуд) характерна для протозойной инвазии.
Осмотр, во время которого часто обнаруживают объективные признаки атопии, диспепсии, интоксикации и эксикоза.
Лабораторная диагностика:
- общий анализ крови (обнаруживают повышение уровня эозинофилов и железодефицитной анемией)
- анализ кала на яйца гельминтов (исключение энтеробиоза или иного гельминтоза)
- копрограмма (определение цист или трофозоитов лямблий)
- иммунофлюоресцентные анализ крови проводят через 2-4 недели после предполагаемого заражения (выявление антител IgM и IgG против лямблий)
- другие серологические анализы крови (определение поверхностных антигенов лямблии).
Инструментальные методы исследования:
- УЗИ органов брюшной полости;
- дуоденальное зондирование;
- фиброэзофагогастродуоденоскопия (микроскопия дуоденального содержимого позволяет выявить вегетативные формы паразита).
Лечение лямблиоза
Лечение детей с данным заболеванием должно быть комплексным, то есть направленным не только на удаление возбудителя, но и на профилактику повторного заражения:
Для этиотропного лечения используют антипротозойные препараты, для предотвращения осложнений (интоксикации) назначают осмотические слабительные препараты, сорбенты и пр. Например, с целью ликвидации гастроинтестинального синдрома применяют энтеросорбенты, ферменты, спазмолитики, антигистаминные препараты. Медикаментозное лечение также может быть направлено также на коррекцию функции органов ЖКТ. В зависимости от типа нарушения работы органа (гипокинетический или гиперкинетический), применяют холеретики, холекинетики, спазмолитики. Лечение аллергического компонента лямблиоза (атопический дерматит, крапивница и т.п.) предусматривает назначение антигистаминных средств (в тяжелых случаях – кортикостероидов).
Вспомогательная терапия. У детей с лямблиозом часто идентифицируют синдромы мальабсорбции. Для их устранения назначают ферменты, витаминно-минеральные комплексы.
Диета. При лямблиозе из рациона ребенка исключают сахар, а также цельное молоко и кисломолочные продукты. Рекомендуемые волокнистые каши на воде.
Режим. Прежде всего важно соблюдать элементарные правила гигиены: мыть руки с мылом после улицы, игры с животными или посещения туалета. Родители также должны полностью исключить пути заражения лямблиозом: все игрушки и предметы ухода за ребенком следует тщательно обрабатывать.
Осложнения и последствия лямблиоза
Проведение неполной эрадикации возбудителя индуцирует развитие хронической формы лямблиоза. При этом может возникнуть рецидив паразитарного заболевания и обострения клинических проявлений.
- синдром мальабсорбции;
- нарушение микрофлоры кишечника;
- стеаторея – выделение избыточного количества жира с каловыми массами;
- аллергические реакции ( в т.ч. атопический дерматит, отек Квинке, анафилаксия);
- нарушения функции желчного пузыря и других органов ЖКТ.
Последствия лямблиоза поддаются медикаментозной коррекции, и в большинстве случаев проходят после полного выведения возбудителя из организма.
Источник:
- Категорії статей
- Інвалідність
- Інфекційні захворювання
- Акушерство, гінекологія, репродуктивна медицина
- Алергія
- Варікоз
- Гастроентерологія
- Гепатологія
- Головний біль
- Депресія. Психотерапія
- Дерматокосметологія
- Дитяча і підліткова гінекологія
- Дитяче харчування
- Ендокринологія. Цукровий діабет
- Кардіологія
- Мамологія
- Надлишкова вага. Дієти
- Неврологія
- Онкологія
- Отоларингологія
- Офтальмологія
- Проктологія
- Пульмонологія, фтизіатрія
- Стоматологія. Захворювання порожнини рота
- Травматологія і ортопедія
- Урологія і нефрологія
- Школа здоров'я
- Щеплення
